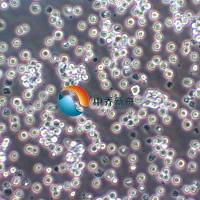
EOL-1人急性髓性(嗜酸性粒细胞)白血病细胞

人嗜酸性粒细胞趋化因子(Eotaxin)ELISA试剂盒 说明书
互联网
人嗜酸性粒细胞趋化因子 (Eotaxin)ELISA 试剂盒
( 用于血清、血浆、细胞培养上清液和其它生物体液内 )
原理
本实验采用双抗体夹心 ABC-ELISA 法。用抗人 Eotaxin(CCL11) 单抗包被于酶标板上,标准品和样品中的 Eotaxin与单抗结合,加入生物素化的抗人 Eotaxin ,形成免疫复合物连接在板上,辣根过氧化物酶标记的 Streptavidin 与生物素结合,加入底物工作液显蓝色,最后加终止液硫酸,在 450nm 处测 OD 值,Eotaxin 浓度与 OD 值成正比,可通过绘制标准曲线求出标本中Eotaxin 浓度。
试剂盒组成 ( 2-8 ℃保存)
|
酶标 板 (Coated Wells ) |
96 孔 |
酶标抗体工作液(Enzyme Conjugate ) |
12ml |
|
10 ×标本稀释液(Sample Buffer ) |
12ml |
20×浓缩洗涤液( Wash Buffer ) |
50ml |
|
标准品 (Standards ) : 20ng/瓶 |
2 瓶 |
底物工作液(TMB Solution ) |
12ml |
|
第一抗体工作液( Biotinylated Antibody ) |
12ml |
终止液 (Stop Solution ) |
12ml |
准备试剂与收集血样
1. 收集标本:血清、血浆(EDTA 、柠檬酸盐、肝素抗凝)、细胞培养上清液、组织匀浆等尽早检测, 2-8 ℃ 保存48 小时;更长时间须冷冻( -20 ℃或 -70 ℃ )保存,避免反复冻融。
2. 标准品液配制:使用前加入1ml 蒸馏水 混匀,配成 2 0ng/ml 的溶液 。 设标准 管 8 管,第一管加标本稀释液 900ul ,第二至第八管加入标本稀释液 500ul 。在第一管中加入 2 0ng/ml 的标准品溶液 100ul 混匀后用加样器吸出 500ul ,移至第二 管 。如此反复作对倍稀释,从第七 管 中吸出 500ul 弃去。第八 管 为空白对照。
3. 10× 标本稀释液用蒸馏水作 1: 1 0 倍稀释( 示例: 1ml浓稀释液 +9ml 蒸馏水)。
4. 洗涤液:用重蒸水 1:20 稀释(示例:1ml 浓缩洗涤液加入 19ml 的重蒸水)
检测程序
1. 加样:每孔各加入标准品或待测样品 100ul ,将反应板充分混匀后置 37 ℃ 120 分钟。
2. 洗板:用洗涤液将反应板充分洗涤 4-6 次,向滤纸上印干。
3. 每孔中加入第一抗体工作液10 0ul 。将反应板充分混匀后置 37 ℃ 6 0 分钟。
4. 洗板:同前。
5. 每孔加酶标抗体工作液100ul 。将反应板置 37 ℃ 3 0 分钟。
6. 洗板:同前。
7. 每孔加入底物工作液100ul ,置 37 ℃ 暗处反应15 分钟。
8. 每孔加入100ul 终止液混匀。
9. 30分钟内用酶标仪在 45 0 nm 处测 吸光值。
结果计算与判断
1. 所有 OD 值都应减除空白值后再行计算。
2. 以标准品20 00 、100 0 、500 、 250 、 125 、 62.5 、 31.2 、 0 pg /ml 为横坐标, OD 值为纵坐标,在坐标纸上作图,画出标准曲线。
3. 根据样品 OD 值在该曲线图上查出相应 Eotaxin 含量 即可 。
试剂盒性能
1. 灵敏度 : 最小的Eotaxin 检测浓度小于 15 pg/ml。
2. 特异性: 可同时检测重组或天然的人 Eotaxin 。 不与 人其它细胞因子有交叉反应。
3. 重复性:板内、板见变异系数均小于10.6%。
注意事项
1. 以上标准孔及待 测 样品均建议做复孔,每次测定应同时 做 标准曲线。
2. 洗涤过程 很关键。洗涤不充分将导致精确度误差及 OD 值错误地升高。
3. 板条开封后剩余板条要再封好,保持 板条干燥 。
4. 本试剂盒宜置 4 o C冰箱保存。
5. 本试剂盒仅用于科研,不能用于临床诊断!